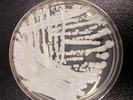

Susan Brink appears in the following:
Child Deaths Drop From 14.2 Million In 1990 To 7.3 Million In 2015
Monday, April 03, 2017
That's the encouraging news in a new report. But it also means more kids are living long enough to face a host of serious challenges to their physical and mental health.
In Sweden, Hundreds Of Refugee Children Gave Up On Life
Thursday, March 30, 2017
An article in this week's New Yorker writes about youngsters who fell into a comalike state in reaction to the news that their family may be deported. We interview the author.
Study: A New Strategy To Stop Female Genital Mutilation
Monday, February 06, 2017
Efforts to stop the practice have focused on health risks. And yet it remains widespread. A new study may explain why.
Contest For Biz Students Is All About Umbilical Cords
Wednesday, February 01, 2017
Students from 11 business programs around the U.S. came together to see who could make the best business plan to address infant mortality in Nigeria.
New Medical Worry: Deadly Fungal Infection That Resists Treatment
Tuesday, January 24, 2017
Candida auris first was identified in Japan in 2009 and now has been found in five continents.
A Superbug That Resisted 26 Antibiotics
Tuesday, January 17, 2017
How close are we to the point when a bacterial infection can resist all available antibiotics? A case in Nevada, reported this past week in the CDC journal, says that we're already there.
Why Doctors Without Borders Is Adding Food To Its Medical Bag
Wednesday, January 11, 2017
In Nigeria, the food crisis is so severe that when MSF sees families to treat disease or provide vaccinations, they're starting to distribute food as well.
How Is The World Treating People With Disabilities?
Sunday, December 18, 2016
A new report from the UCLA Fielding School of Public Health looks at how far countries have come — and have far they still have to go.
Liver Cancer Is Becoming A Top Killer In Poor Countries
Friday, December 09, 2016
It's one of the cancers highlighted in a new report that looks at the growing number of cases worldwide.
Moroccan TV Tutorial: How To Cover Up Bruises From Domestic Abuse
Saturday, December 03, 2016
The station has since apologized for the segment. But researchers say it reflects local attitudes toward domestic violence.
What's The Prognosis For $3 Billion Zuckerberg Health Plan?
Friday, September 23, 2016
The goal of curing all diseases "in our children's lifetime" sounds a lot like hype. But is it? It's the goal of Facebook founder Mark Zuckerberg and his pediatrician wife, Priscilla Chan.
What Doctors Learned From 42 Infants With Microcephaly
Wednesday, September 14, 2016
A new study from Brazil provides an early snapshot of what the future could hold for children infected with Zika, then born with the brain defect.
Unwelcome Surprise: A Disease-Spreading Chigger Turns Up In Chile
Saturday, September 10, 2016
The mite larvae that transmit scrub typhus were thought to live only in parts of Asia and Australia. Now three cases have been reported in an island off Chile's coast.
Yellow Fever Timeline: The History Of A Long Misunderstood Disease
Sunday, August 28, 2016
An outbreak in Angola and the Democratic Republic of Congo has raised concerns about the infamous and fearsome disease — once a scourge of the U.S., Panama and Spain.
What Should Vacationers Pack In Their Travel Medical Kit?
Saturday, June 18, 2016
What supplies will the health-conscious traveler pack to keep illness at bay? We asked the experts.
If We Could #BringBackOurGirls, They Might Not Be Welcomed With Open Arms
Thursday, April 14, 2016
Some of the girls and women abducted by Boko Haram have escaped or been rescued. But freedom does not mean an end to their ordeal.
A Global Alarm About Diabetes — And Don't Blame It All On Fast Food
Thursday, April 07, 2016
The results of the first coordinated global look at the disease show a dramatic increase, especially in low- and middle-income countries.
What Makes Water Unsafe? Not The Color, Taste Or Smell: #WorldWaterDay
Tuesday, March 22, 2016
For millions around the world, it's the invisible microbes and parasites that can turn their daily drinking water into a dangerous elixir.
Studies Reinforce The Urgency Of Treating Pregnant Women With Malaria
Wednesday, March 09, 2016
The world is focused on finding a link between pregnant women infected with the Zika virus and severe birth defects. But two studies and an editorial in this week's New England Journal of Medicine are reminders that malaria, a disease that killed about half a million people in 2015, also ...
What's The Best Way To Keep Mosquitoes From Biting?
Saturday, January 30, 2016
Don't get bitten by mosquitoes.
That's the advice offered to the public in virtually every article on the rapidly-spreading, mosquito-borne Zika virus.
There's no arguing with the advice. Zika, once considered a relatively mild flu-like illness, has now been linked to a surge in severe birth defects in Brazil and ...